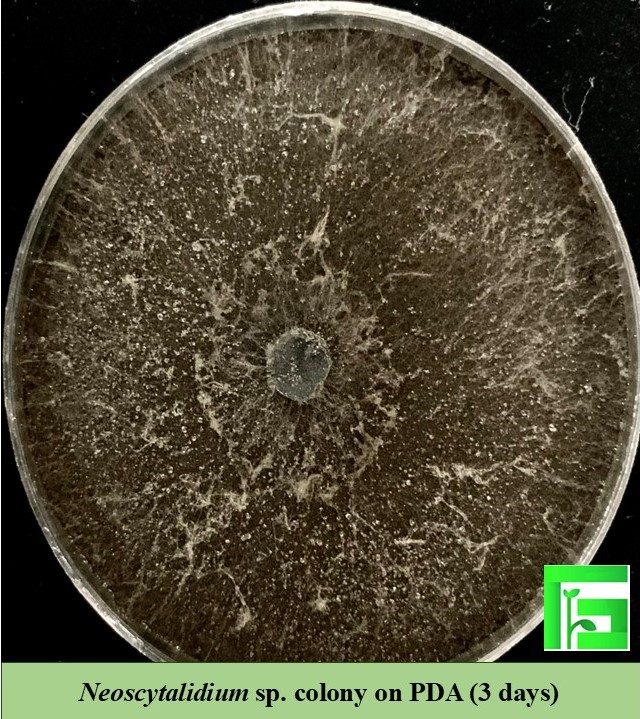

The symptoms included leaf margin necrosis, branch and trunk rot, and ultimately, tree decline

Banana stem, dark and black lesions on the outer and inner bark, vascular discoloration and brown rot on main stem
Picture of one of eight fungal isolates, which was isolated from infected tree trunk to Neoscytalidium sp. on PDA.
We are an agrochemical company in Iran specializing in fungal pathogens, mycology, and inorganic fungicides. With strong investment in R&D, we are a leading private-sector player in identifying plant diseases and fungal threats across the country.